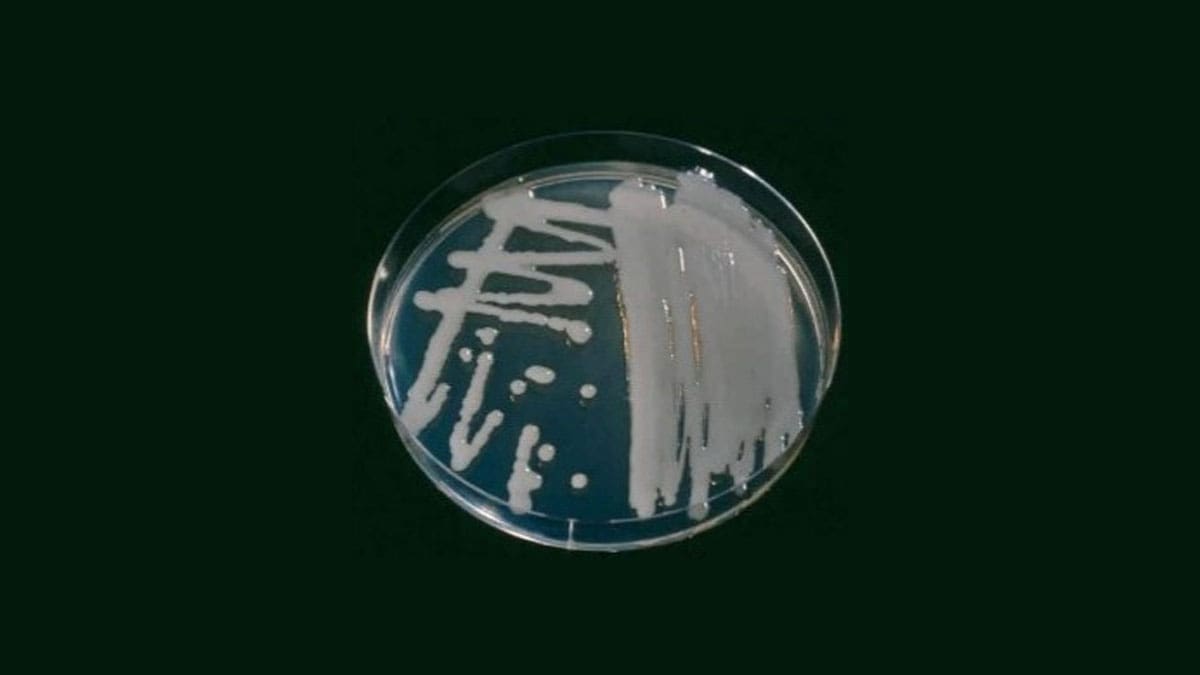
رشد Erwinia amylovora روی محیط کشت King’s B
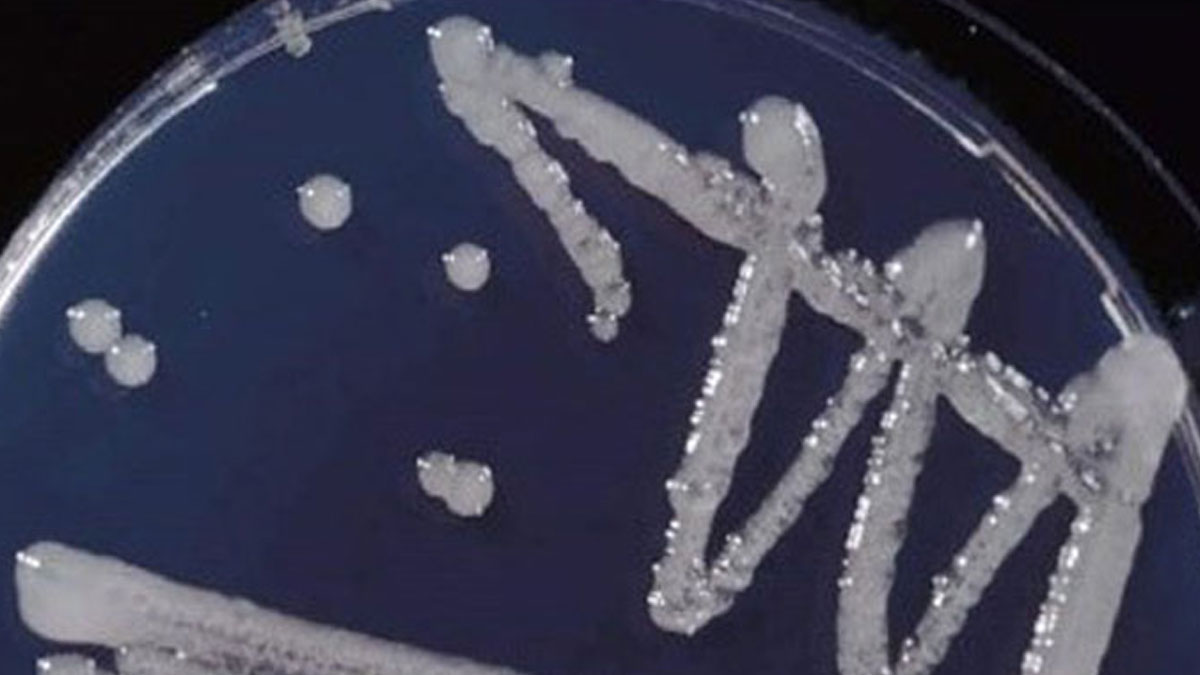
رشد باکتری Erwinia amylovora روی محیط کشت CCT
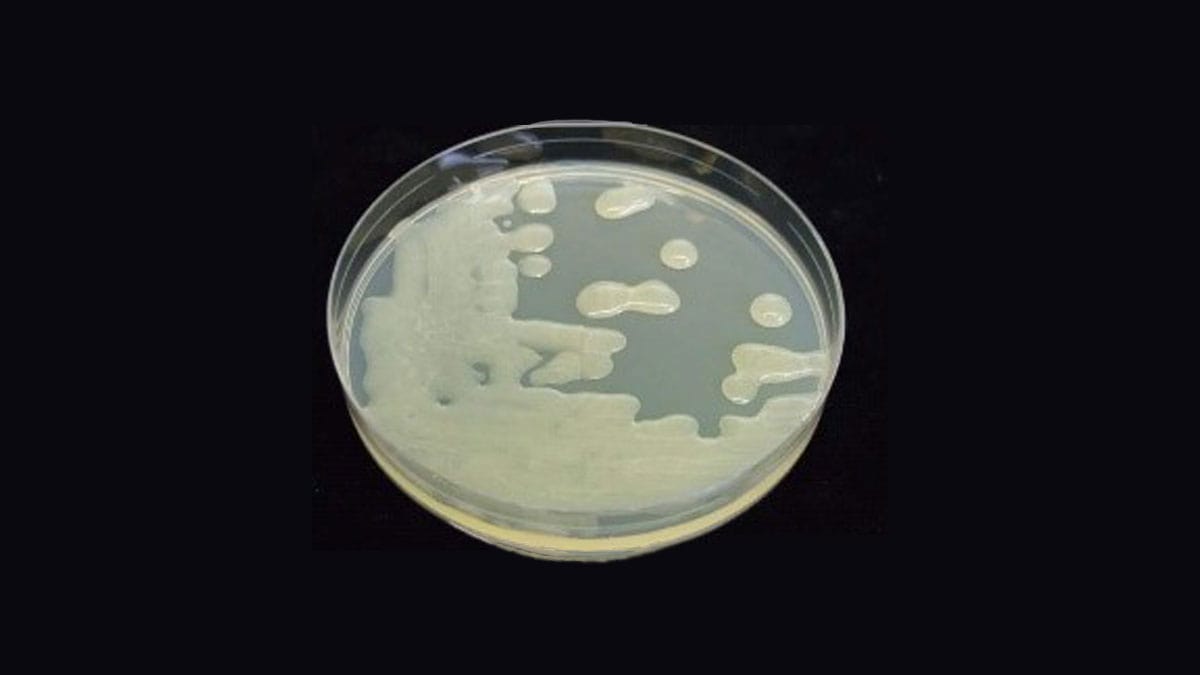
ریخت‌شناسی معمول کلنی Erwinia amylovora روی محیط کشت لووان (NSA)

بیماری آتشک در گیاهان: علائم، عوامل ایجادکننده و روشهای کنترل مؤثر
بیماری آتشک در گیاهان ، یک بیماری باکتریایی بسیار مسری است که معمولاً اعضای خانوادهی گلسرخیان (Rosaceae) را درگیر میکند؛ بهویژه درختان سیب، گلابی، به و برخی گیاهان زینتی.
این بیماری با ایجاد ظاهری سوخته در بخشهای آلودهی گیاه شناخته میشود. منشأ آن آمریکای شمالی است، اما با گذر زمان در سراسر جهان گسترش یافته و خسارات شدیدی به باغهای میوه در اروپا، آسیا و بسیاری از مناطق دیگر وارد کرده است. بیماری آتشک موجب کاهش شدید محصول، افزایش هزینههای مدیریت و در نهایت مرگ درخت میشود و به همین دلیل زیان اقتصادی هنگفتی را به صنعت میوهکاری وارد میکند.
اما دقیقاً چه عواملی باعث بروز آتشک میشوند و چگونه میتوان از گسترش آن جلوگیری کرد؟ در بخشهای بعدی به پاسخ این پرسشها خواهیم پرداخت.
عامل ایجادکنندهی بیماری آتشک در گیاهان

عامل اصلی بیماری آتشک در گیاهان، باکتریای به نام Erwinia amylovora است که میلهای شکل است، در گروه باکتریهای گرممنفی قرار میگیرد و عضوی از خانوادهی Enterobacteriaceae محسوب میشود.

این باکتری دارای تاژکهای محیطی (Peritrichous flagella) است و یک پلیساکارید خارجسلولی بسیار چسبناک به نام لوان (levan) ترشح میکند.
این ماده نوعی پلیساکارید است که در ترشحات چسبندهی حاصل از بافتهای آلوده وجود دارد و با تشکیل پوششی محافظ روی باکتری، به بقای آن کمک میکند.
این پوشش یا بیوفیلم، به باکتری امکان میدهد مدت بیشتری زنده بماند و به بافتهای گیاه بچسبد. علاوه بر این، باکتری عوامل بیماریزایی (Virulence Factors) متعددی ترشح میکند که در روند آلودگی نقش مهمی دارند.
باکتری عامل بیماری آتشک در گیاهان نهتنها درون بافتهای آلودهی گیاه زنده میماند، بلکه روی سطوح گوناگون گیاه نیز دوام میآورد. همین ویژگی باعث میشود بتواند خود را با شرایط محیطی متنوعی تطبیق دهد.
علائم بیماری آتشک در گیاهان
علائم بیماری آتشک در گیاهان، بسته به بخشهای مختلف گیاه که آلوده شدهاند، متفاوت است. شناخت دقیق این علائم برای تشخیص سریع و پیشگیری از گسترش بیماری ضروری است. در ادامه، نشانههای آتشک در هر قسمت از گیاه بهصورت جداگانه توضیح داده شده است.
1. مرگ شکوفهها (Blossom Blight)
یکی از اولین نشانههای بیماری آتشک در گیاهان، پژمردگی و تغییر رنگ شکوفهها است. در ابتدا شکوفهها حالتی آبدار و مرطوب دارند، اما با پیشرفت بیماری، پژمرده و به رنگ قهوهای یا سیاه در میآیند و ظاهری سوخته پیدا میکنند. گلهای آلوده ترشح باکتریایی (ooze) دارند که از ویژگیهای بارز آتشک محسوب میشود و میتواند به عنوان منبع عفونت برای آلودگیهای بعدی عمل کند.
2. مرگ شاخهها (Shoot Blight)
در شاخههای آلوده، نوک شاخهها خمیده، پژمرده و خشک میشوند و حالتی مشخص به نام قلاب چوپان (Shepherd’s Crook) پیدا میکنند. برگهای آلوده اغلب سوخته به نظر میرسند و به رنگ سیاه یا قهوهای تیره درمیآیند. روی گلآذینها و شاخههایی که به همراه بارش باران، پاشش قطرات، یا انتقال توسط حشرات آلوده میشوند، ممکن است ترشحات باکتریایی روی ساقهها و برگها دیده شود.
3. ایجاد زخمهای ساقه (Cankers Formation)
با حرکت باکتریها به شاخهها، زخمهای فرورفته و تغییر رنگ یافتهای روی پوست درخت ایجاد میشود که معمولاً قهوهای یا سیاه هستند.
این زخمها میتوانند شاخهها و ساقهها را احاطه کرده و منجر به خشک شدن بخشهای بیشتری از گیاه شوند. زخمها میتوانند در طول زمستان با حضور باکتری زنده بمانند و در فصل رشد بعدی موجب آلودگی مجدد گیاه شوند.
4. مرگ یا آسیب میوهها (Fruit Blight)
در میوههای آلوده، لکههای تیرهای ظاهر میشوند که ابتدا آبدار هستند و سپس به رنگ سیاه درمیآیند. این میوهها ممکن است ترشحات باکتریایی از خود آزاد کنند و در نهایت قبل از رسیدن کامل، کوچک شده و از درخت بیفتند که منجر به کاهش قابل توجه محصول میشود.
5. مرگ یا آسیب پایهی ریشه (Rootstock Blight)
باکتریها میتوانند به پایهی ریشه درختان جوان نفوذ کنند، بهویژه زمانی که نهالها روی پایههای حساس پیوند زده شدهاند. در چنین مواردی، گیاه به سرعت ضعیف شده و ممکن است کل درخت خشک شود. عفونتهای پایهی ریشه ماهیتی کشنده دارند، زیرا باکتریها میتوانند بهطور کامل اطراف پایه را فرا گرفته و گیاه را از بین ببرند.
چرخهی بیماری آتشک در گیاهان
چرخهی بیماری آتشک شامل مراحل مختلفی است که در ادامه توضیح داده میشوند:
بقای باکتری در طول زمستان
باکتریها زمستان را در شاخههای آلوده و در لبهی زخمها (cankers) سپری میکنند. در فصل بهار، زمانی که دما به حدود ۶۵ درجه فارنهایت (۱۸ درجه سانتیگراد)، باکتریها به سرعت تکثیر میشوند. تودههای باکتری از شکافها و روزنههای پوست درخت خارج شده و ترشحی شیرین و چسبناک به نام ترشح باکتریایی (bacterial ooze) تشکیل میدهند.
حشراتی مانند شتهها، مورچهها، زنبورها، سوسکها و مگسها به ترشح باکتریایی جذب میشوند. باکتری را بر روی بدن خود حمل کرده و آن را به شکوفههای باز منتقل میکنند. باران نیز با پخش کردن این ترشحات، باعث گسترش بیشتر بیماری میشود.

آلودگی اولیه (آلودگی شکوفهها)
بیشتر آلودگیهای اولیه در قسمت شکوفهها اتفاق میافتد، جایی که باکتری از طریق منافذ طبیعی گل به نام نکتاری (nectaries) وارد گیاه میشود. این باکتری ابتدا در بافتهای گل رشد کرده و سپس به سمت شاخهها و ساقهها پیشروی میکند. هنگامی که باکتری بافت کامبیوم (cambial tissue) شاخه را مورد تهاجم قرار داده و از بین میبرد، تمام گلها، برگها و میوههایی که در بالای ناحیهی آلوده قرار دارند، میمیرند.
علاوه بر شکوفهها، آلودگی ممکن است از طریق روزنههای طبیعی برگ (stomata)، عدسکهای موجود روی شاخهها (lenticels)، زخمهای حاصل از هرس، تغذیه یا تخمگذاری حشرات و حتی آسیب ناشی از تگرگ نیز رخ دهد.
آلودگی ثانویه و انتشار بیماری
زنبورها از مهمترین ناقلان باکتری Erwinia amylovora هستند و با جابهجا کردن ترشحات باکتریایی از گلهای بیمار به گلهای سالم، باعث گسترش بیماری میشوند. علاوه بر آن، حشراتی مانند مگس و مورچه نیز در انتقال این ترشحات نقش دارند. باد و باران هم میتوانند این مواد را به گیاهان اطراف پخش کنند و به این ترتیب، چرخههای آلودگی ثانویه شکل میگیرد. وقتی باکتری در داخل گیاه مستقر شود، از طریق آوندها حرکت کرده و سایر بخشها را آلوده میکند که منجر به زخمهای پوستی و خشکیدگی شاخهها میشود. در شرایط شدید آلودگی، باکتری ممکن است به سمت پایهی ریشه حرکت کند و باعث ایجاد عفونت سیستمیک در کل گیاه شود. بهویژه در درختان جوان یا پیوندی با پایههای حساس.
تأثیر شرایط محیطی و الگوی گسترش بیماری آتشک در گیاهان

شرایط محیطی متعددی بر شدت و گسترش بیماری آتشک در گیاهان تأثیر میگذارند که در ادامه به آنها اشاره شده است:
دما
بیماری آتشک در دماهای بالا رشد و گسترش مییابد. بهترین دما برای رشد باکتری عامل این بیماری بین ۲۴ تا ۲۷ درجه سانتیگراد است. درنتیجه بیشترین موارد شیوع بیماری معمولاً در فصل بهار و اوایل تابستان، یعنی دورههای گرم سال، اتفاق میافتد.
رطوبت
این بیماری برای پیشرفت به رطوبت نسبی بالای ۶۰٪ نیاز دارد. بارندگی شدید و آبیاری باعث ایجاد شرایط مرطوب و اشباع شدن بافتها از آب میشوند که موجب تکثیر باکتری و گسترش ترشحات باکتریایی میشود. پاشش قطرات ناشی از باران یا آبیاری، انتقال باکتری به بافتها و گیاهان جدید را تسهیل کرده و در انتشار بیماری نقش مهمی دارد.
تگرگ، باد و طوفان
تگرگ، باد و طوفان میتوانند به سطوح گیاهان آسیب وارد کنند. باکتریها از این طریق به گیاه نفوذ کرده و در آن باقی میمانند. بارندگی شدید و روزهای گرم، شرایط ایدهآلی برای شیوع بیماری آتشک در گیاهان ایجاد میکند.
راهکارها و روشهای کنترل بیماری آتشک در گیاهان

کنترل بیماری آتشک در گیاهان باید بهصورت جامع و ترکیبی انجام شود و شامل اقدامات کشاورزی و مدیریتی، استفاده از مواد شیمیایی، کنترلهای بیولوژیکی و پرورش گیاهان مقاوم به آتشک باشد.
اقدامات مدیریتی و کشاورزی (Cultural Practices)
هرس و رعایت بهداشت: برای محدود کردن گسترش بیماری، شاخهها و زخمهای آلوده باید مرتب هرس شوند. پس از هرس، ابزارها باید ضدعفونی شوند تا باکتریها به سایر بخشها منتقل نشوند. شاخهها و زخمهای هرسشده باید یا سوزانده شوند و یا از باغ دور شوند.
اجتناب از مصرف بیش از حد کودها: استفادهی بیش از حد از کودهای نیتروژنی باعث رشد زیاد شاخههای جدید میشود که در برابر آلودگی حساس هستند. بنابراین، مصرف نیتروژن باید به حد اعتدال انجام شود تا تعداد شاخههای آسیبپذیر کاهش یابد.
ایجاد فاصله کافی بین درختان: درختان باید با فاصلهی مناسب کاشته شوند تا جریان هوا در بین آنها برقرار شود. سطح گیاهان خشکتر، رطوبت کمتری دارد و در نتیجه شرایط مناسبی برای فعالیت باکتری ایجاد نمیکند.
کنترل شیمیایی بیماری آتشک در گیاهان
آنتیبیوتیکها: از میان آنتیبیوتیکهای مختلف، استرپتومایسین پرکاربردترین دارو در مدیریت بیماری آتشک است. استفاده از این دارو در زمان باز شدن شکوفهها، تعداد باکتریها روی گلها را کاهش داده و مانع بروز آلودگی اولیه میشود.
محلولهای مسی: استفاده از ترکیبات مس یکی از روشهای پیشگیری مؤثر برای از بین بردن باکتریها روی سطوح گیاه هستند. این محلولها معمولاً در اوایل بهار و قبل از باز شدن شکوفهها استفاده میشوند. با این حال، باید مراقب بود، زیرا مس میتواند باعث آسیب و سمیت برگهای جوان شود.
کنترل بیولوژیکی بیماری آتشک در گیاهان
باکتریهای مفید: تحقیقات نشان دادهاند که برخی باکتریها، مانند Pseudomonas fluorescens و Bacillus subtilis، فعالیت باکتری عامل آتشک را مختل میکنند. این تداخل باعث کاهش فعالیت عامل بیماری و در نتیجه مهار بیماری آتشک میشود.
محصولات مخمری: برخی مخمرها در برابر E. amylovora روی سطوح گیاه مقاوم هستند. این مخمرها برای محیط زیست ایمن و بدون خطر هستند و میتوانند به جای سموم شیمیایی استفاده شوند.
گیاهان و پایههای مقاوم به بیماری آتشک: برخی از گونههای سیب و گلابی نسبت به بیماری آتشک مقاومت نسبی دارند. این نوع گیاهان مقاوم، علائم و خسارت کمتری به همراه دارند.
برخی پایههای ریشه نسبت به بیماری آتشک مقاوماند. بهعنوان مثال، پایههای سری Geneva مانند Geneva 11 و Geneva 16 مقاوم هستند.
رصد و کنترل منظم وضعیت گیاهان
زمانهایی که دما و رطوبت برای رشد باکتری مناسب است، باید گیاهان را به دقت تحت نظرداشت. استفاده از مدلهای مختلف پیشبینی بیماری به شناسایی احتمال وقوع آلودگی بر اساس دما، رطوبت و مرحله شکوفهدهی کمک میکند و امکان بهرهگیری فوری از اقدامات حفاظتی را فراهم میآورد.
بهکارگیری ترکیبی روشهای کنترل بیماری
با استفاده از محلولهای مسی، آنتیبیوتیکها و عوامل بیولوژیکی به صورت متناوب احتمال ایجاد مقاومت بسیار کم است، زیرا هیچ یک از این گروهها بهطور مکرر و بیش از حد استفاده نمیشوند.
جمع بندی
بیماری آتشک در گیاهان یکی از جدیترین بیماریهایی است که در سطح جهان میوههای هستهدار را تحت تأثیر قرار میدهد. این بیماری به دلیل توانایی زنده ماندن در زخمها در طول زمستان، شدت بیماریزایی بالا و قابلیت نفوذ به بیشتر بافتهای گیاهی، مشکل بزرگی محسوب میشود. مدیریت یکپارچه که از روشهای باغبانی، شیمیایی، بیولوژیکی و ژنتیکی استفاده کند، میتواند بهترین گزینه برای کاهش اثرات بیماری آتشک باشد.






